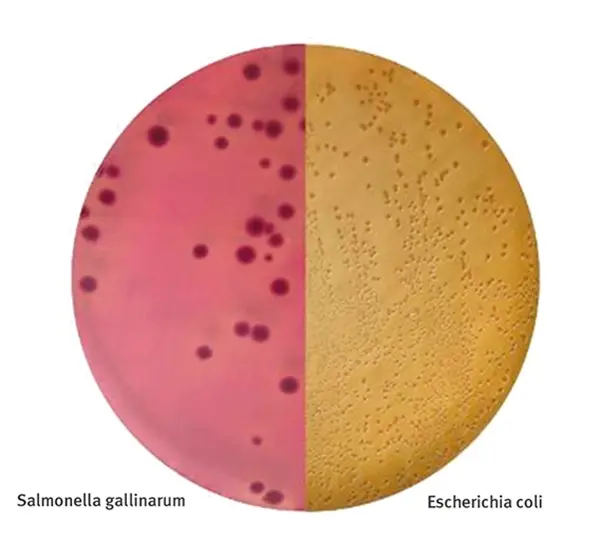

Unité de vente : 20
Marque : Hygiplus
Référence fabricant : 049120
Code NACRES : NA.74
Connaître la disponibilité ?Connectez-vous
26,20 €

Vous allez être redirigé vers l'interface de votre navigateur dédiée à l'impression et à l'enregistrement en PDF.
Sélectionnez l'option qui vous convient dans le menu déroulant "Destination".
Usager UGAP ? Cliquez ici pour voir l’article sur ugap.fr
Usager UGAP ? Cliquez ici pour voir l’article sur ugap.fr